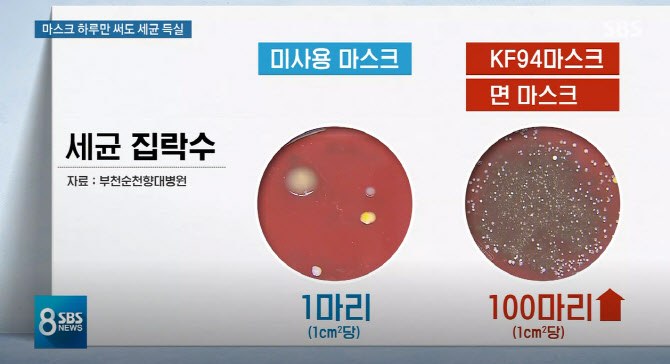
PS20072500146.jpg

마스크는 얼마나 자주 바꿔야 할까?
미생물 상담소 [Ep.15] 마스크 바꾸는 주기

우와, 오늘은 서비스업에 종사하시는 사연자님의 고민이네요!

안녕하세요. 코로리예요!
오늘 비가 종일 오는데 다들 뭘하며 시간을 보내셨는지 궁금하네요.
요즘은 코로나19 바이러스 확진자 수 많이 줄기는 했지만 여전히 실내에서는 마스크를 써야 하죠. 여러분들은 마스크 얼마나 자주 바꾸시나요? 마스크에 뭐가 묻지 않으면 일주일 이상 쓰시는 분들도 있다고 들었는데요. 일주일 동안 마스크를 안 바꿔도 되는 걸까요?
'일회용 마스크를 재사용해도 되는가?'에 대한 WHO의 답변은 'NO'입니다! WHO는 일회용 마스크를 재사용하지 말고, 마스크에 습기가 차면 즉시 새것으로 교체하라고 권고하였는데요. 마스크에 남아있는 세균이 감염원이 될 수 있기 때문이라고 덧붙였어요. 숨을 쉬면서 자연스레 마스크 안쪽의 온도와 습도가 높아지기 때문에 세균이 쉽게 자랄 수 있기 때문이에요. 순천향대 진단검사의학과 교수님에 따르면 KF94 마스크는 바이러스 차단율이 높은데, 이는 곧 통기성은 떨어진다는 의미기 때문에 KF94 마스크 안쪽에서 세균이 더 많이 검출됐을 가능성이 크다고 말씀하셨어요.

SBS ‘뉴스8’은 KF94와 비말 차단, 면, 덴탈 등 네 종류의 마스크에 관한 실험을 했더니 다량의 세균이 발견됐다고 보도했어요. 네 종류의 마스크를 각각 쓰고 1km를 걷게 한 뒤 100m 단위로 마스크 안쪽 습도를 측정해보았더니 네 종류 마스크 모두 세균 검출률 80%를 웃돌았어요. 피부와 입안에서 서식하는 균들이 검출되었고, 면마스크와 KF94 마스크에서 가장 많은 세균이 나왔고 일부 마스크에서는 슈퍼박테리아라 불리는 항생제 내성균도 검출됐다고 해요. 밑의 자료화면을 보면 미사용 마스크와 하루 정도 사용한 마스크의 세균 검출량을 비교할 수 있답니다.
실험을 통해 알 수 있는 사실은 마스크 안쪽의 습도와 온도 역시 높아진다는 것인데요. 습도는 대기의 습도의 2배에 가까운 수준으로 꽤나 습한 것을 알 수 있고, 마스크 안쪽의 온도는 피부 표면보다 최고 2도 이상 높았다는 결과가 나왔어요.
마스크의 세균 수 비교 (출처: SBS 뉴스'8' 방송화면)
마스크의 세균 수 비교 (출처: SBS 뉴스'8' 방송화면)마스크를 오래 쓰면 세균의 개체 수가 늘어나고, 이 많은 세균이 우리 피부와 입 안으로 들어오겠죠. 코로나19 바이러스를 막기 위해 마스크를 쓰지만 더러운 마스크를 오래 쓰면 오히려 기관지에 문제가 생긴답니다. 그러니 마스크 비용이 조금 들더라도, 우리의 기관지 건강을 위해 일회용 마스크는 재사용하지 말자고요.
오늘도 [미생물 상담소]에 놀러 와주셔서 감사하고, 남은 시간 미미하고 소소한 하루 보내세요!